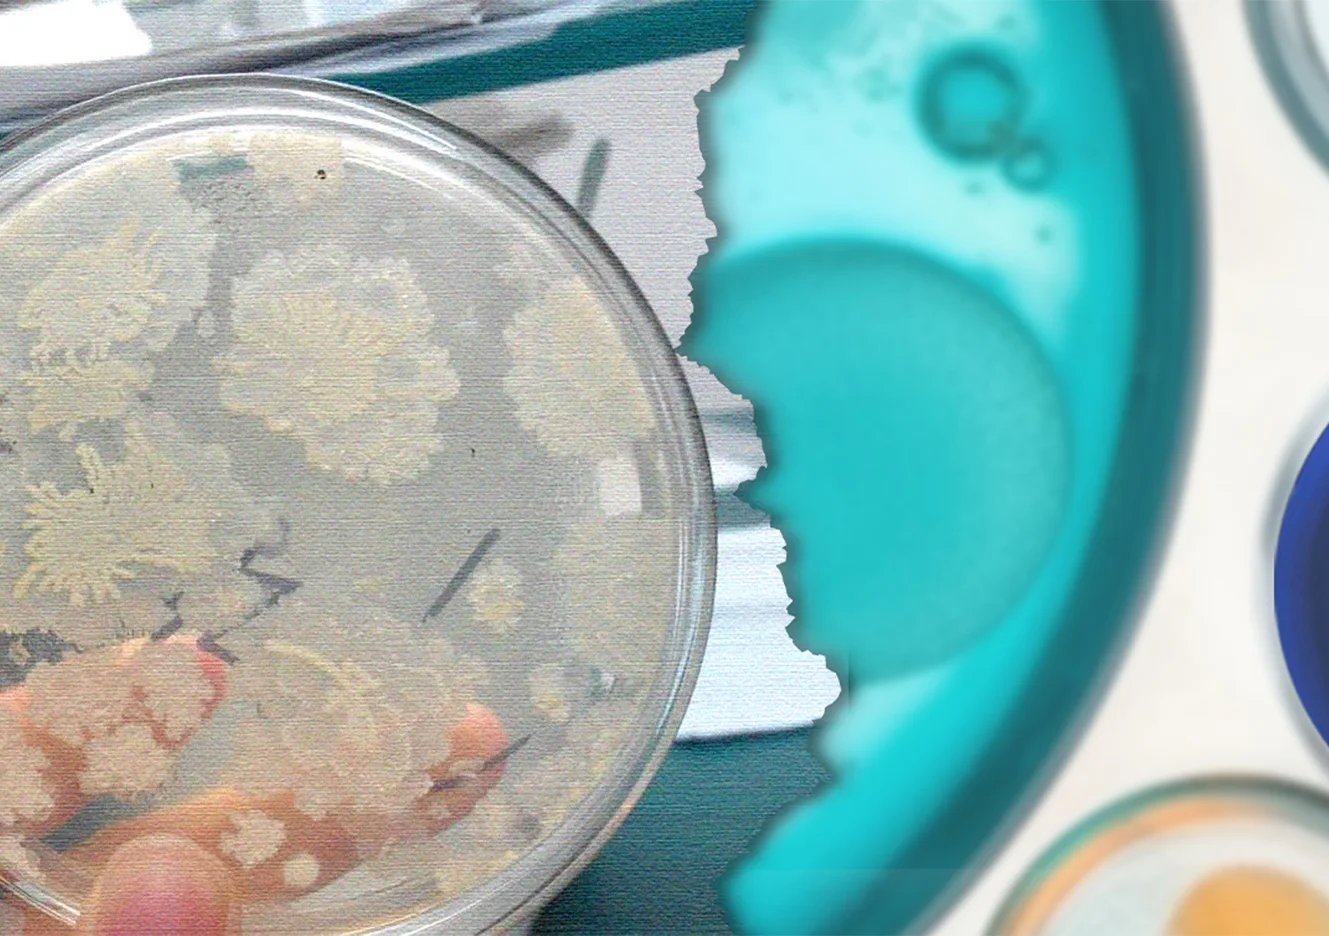

Home > News
News
Featured
Tailin Bioengineering 5th Listing Anniversary & 2024 Annual Awards Ceremony
Tailin Strategic Outlook: Celebrating 2024 Success & Charting the Path for 2025. As we conclude a landmark year, Chairman Mr. Ye Dalin shared a powerful vision for Tailin’s future. Reflecting on our 2024 achievements, he credited our success to the resilience and innovation of our entire team.